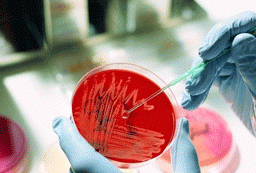

黑色素三日快速激活疗法,作为中美SKS重点临床科研项目,结合上万例康复患者,找到了人体诱发基因病变的环境,通过纳米透视技术进行黑色素微化渗入;能一次性激活治好各种顽固性白斑。为了让给多的患者朋友能享受到中美SKS白癜风研究院科研成果,河北远大中医皮肤病医院(1)即日起对每天网络预约前10名患者可享受免费全程白癜风体检(仅限 10个平方厘米),专家会诊费用全面,活动期间可以享受白癜风预防健康手册一本。(2)对于外省患者来我院治疗一律报销往返硬座车票,火车站免费专车接送。





干细胞技术作为21世纪先进的技术之一,已应用于临床,并取得了较好的疗效。干细胞主要存在于骨髓造血中枢,在外周血中含量很少。骨髓有多种不成熟的细胞,能分化为造血细胞和内皮祖细胞。通过移植直接进入皮肤表皮的干细胞内迅速激活干细胞产生细胞调节因子,能高效分离斑毒侵害的缺陷、变异的细胞,对其进行修复、替换、优化。
 1.病因检测:
1.病因检测:
自体干细胞深度祛白疗法立足于从全面的检查开始,专家根据患者个人的身体状况,利用德国奥曼wood灯……[详情]
 2.植入自体细胞的过程:
2.植入自体细胞的过程:
根据所检查的病因,然后分类、分型、分性、分期制定多维白癜风康复方案。该康复方案由16项核心技术和超百项辅助……[详情]

治疗起效阶段早7天时:
白斑处皮肤向红色、深红色、褐色转变。在病变部位毛孔处出现针尖大小的色素斑点,形状像小岛,称之为"色素岛"。
白斑边缘或中间出现毛囊性黑点,体内黑色素细胞明显增多,病变部位黑色素沉着由周围慢慢向中间聚集,将看到白斑面积逐渐向中间缩小。小面积的白斑可完全恢复,大面积的白斑可恢复皮损面积的70%。此阶段为治疗的强化阶段。
治疗稳固阶段2—3个月
酪氨酸酶的活性正常,黑色素细胞正常代谢,白斑全部消退,恢复正常肤色。但是,因个体差异,个别较为严重的患者治疗相对会延长一段时间。此阶段为治疗的稳固阶段。
治疗巩固阶段3—4个月
在人体酪胺酸酶系统恢复正常功能后,白斑部位完全和正常皮肤相同,但是较为敏感,需巩固治疗。经过这个阶段的巩固治疗后,可有效防止白癜风的复发。



 单一技术,不注重长远疗效。往往疗效慢、疗程长、治好几率低。通过干细胞自主更新、分化能力,注重对症施治的重要性。同时双向调节机体免疫,增加抵抗能力
单一技术,不注重长远疗效。往往疗效慢、疗程长、治好几率低。通过干细胞自主更新、分化能力,注重对症施治的重要性。同时双向调节机体免疫,增加抵抗能力
 一般在一年以上。一般在3个月治疗左右白斑消失。
一般在一年以上。一般在3个月治疗左右白斑消失。
 这种模式往往疗效慢、疗程长、治好几率低,易产生了抗药性、耐药性几乎不产生免疫排斥,成功率高。迅速根除修复白斑,对人体无任何副作用,且治好后不复发,手术危险性小,可操作性强,创伤小
这种模式往往疗效慢、疗程长、治好几率低,易产生了抗药性、耐药性几乎不产生免疫排斥,成功率高。迅速根除修复白斑,对人体无任何副作用,且治好后不复发,手术危险性小,可操作性强,创伤小
 都有很大程度的,破坏了正常皮肤细胞的生长分裂,轻者出现骨质疏松、脱发、恶心等症状对人体无任何副作用,且治好后不复发等优势
都有很大程度的,破坏了正常皮肤细胞的生长分裂,轻者出现骨质疏松、脱发、恶心等症状对人体无任何副作用,且治好后不复发等优势
 单次治疗费用不高,但治疗次数多,总价高。由于治疗疗程少,减少复发率所以总价低于单一治疗的方法。(医院为国家定点医保单位)
单次治疗费用不高,但治疗次数多,总价高。由于治疗疗程少,减少复发率所以总价低于单一治疗的方法。(医院为国家定点医保单位)
 以效果不理想,容易复发。在不破坏皮肤组织的前提下,针对性治疗,从根本上杜绝了复发的可能性。
以效果不理想,容易复发。在不破坏皮肤组织的前提下,针对性治疗,从根本上杜绝了复发的可能性。

 石家庄远大中医皮肤病医院是河北省引进美国Xtrac-308准分子激光治疗系统的白癜风治疗专科医院,美国Xtrac-308准分子激光治疗系统有效的解决了白癜风医疗形势,据记者调查了解308准分子激光治疗系统集成了308nmXeCI准分子激光光源、200Hz的准连续纳米调制、新的液体光源传输(LLG)等多项世界顶级技术。这套治疗系统采用的是XeCI准分子气体,堪称是目前世界皮肤激光治疗系统的颠峰之作。
石家庄远大中医皮肤病医院是河北省引进美国Xtrac-308准分子激光治疗系统的白癜风治疗专科医院,美国Xtrac-308准分子激光治疗系统有效的解决了白癜风医疗形势,据记者调查了解308准分子激光治疗系统集成了308nmXeCI准分子激光光源、200Hz的准连续纳米调制、新的液体光源传输(LLG)等多项世界顶级技术。这套治疗系统采用的是XeCI准分子气体,堪称是目前世界皮肤激光治疗系统的颠峰之作。

第一、白癜风初期患者
第二、白癜风肢端型、节断型、寻常型、毛囊型、局限型患者
第三、被白癜风困扰久治不愈患者
第四、白癜风治疗后反复复发型患者
第五、白癜风幼儿患者等

无痛黑色素细胞复活疗法从患者自体细胞中分离出活性黑色细胞,运用国际前沿的治疗系统将足量的黑色素细胞准确培植与白斑病灶,同时提供多种黑色素营养液,保证黑色素细胞成活,分裂,恢复自我养护功能,终实现轻松消除白斑。

第一、疗效更快
针对患者不同病情,采用个性化治疗方案…… [详情]
第二、更全面、不复发
根本解决白癜风复发的难题,治疗更完善…… [详情]
第三、更安全
该技术是通过患者自身细胞进行种植治疗,所以…… [详情]

 黑色素细胞种植成活疗法,运用世界先进的技术,高度浓缩提纯而成,药效直接作用于血液中,从患者自体细胞中分离出活性黑色细胞,运用国际前沿的治疗系统将足量的黑色素细胞准确种植与白斑病灶,同时提供多种黑色素营养液,保证黑色素细胞成活,分裂,恢复自我养护功能。
黑色素细胞种植成活疗法,运用世界先进的技术,高度浓缩提纯而成,药效直接作用于血液中,从患者自体细胞中分离出活性黑色细胞,运用国际前沿的治疗系统将足量的黑色素细胞准确种植与白斑病灶,同时提供多种黑色素营养液,保证黑色素细胞成活,分裂,恢复自我养护功能。
黑色素细胞神思种植成活疗法,采用了国际先进的基因生物交互作用原理,利用低温效应。使治疗部位神经末梢的髓鞘变性,从而暂时性中断感应传导,而完全消除患者治疗痛苦。利用新型白癜风专用提……

第一、微循环检测,找准病因。
第二、药分子小,直达病灶。
第三、七天除斑,疗效显著。一般患者治疗三天见效,白斑扩散得到控制,难治性的白癜风患者治疗七天后白斑缩小,病情得到好转,回家巩固两个疗程后,可完全治好。
第四、标本兼治,防止复发。大部分患者经治疗后,3—5年不见复发

DD-B白癜风蜕变康复工程——从病因入手,七大检测,9项核心治疗技术,六大优势。开创白癜风治疗新纪元


供皮区选择腹部、臀部、股部等非暴露部位皮肤,采用负压吸引、液氮、局部PUVA照射或者药物刺激等方法使局部皮肤起疱,从而达到真表皮分离的目的。受皮区白斑目前多采用皮肤磨削术将表皮去掉……
[详情]


用取皮刀在供皮区获取约1微米厚度的极薄皮片,从而达到仅取表皮的目的,临床上以稍见点状出血为度。受皮区仍采用磨削法处理,然后用所取皮片覆盖。这种方法的优点是操作简单、手术时间大……
[详情]

集成了308nmXeel准分子激光光源,154HZ的准连续纳秒调制、计算机照射剂量精密控制和新的液体光导传输(LLG)等多项世界顶级技术,与传统的紫外线疗法相比独有显效快速、适用人群广泛、疗效持久、适合各部位治疗、安全可靠。

308准分子激光治疗系统集成了308nmXeCI准分子激光光源、200Hz的准连续纳米调制、新的液体光源传输(LLG)等多项世界顶级技术。这套治疗系统采用的是XeCI准分子气体,堪称是目前世界皮肤激光治疗系统的颠峰之作。

308nm准分子紫外光能抑制T细胞的活性,刺激白癜风毛囊内残余的黑色素细胞增殖、色素分泌及破坏皮肤中的硫氢基而增强酪氨酸酶的活性、使黑色素小体数量增加,从而达到治疗白癜风的效果。

黑色素细胞种植疗法简单说就是再生黑色素细胞,并使其在白斑部位成活繁衍。这种技术适用于白斑的相对稳定期,该技术无需麻醉、无任何痛苦及副作用,确保提取到优质活跃的黑色素细胞;并使黑细胞快速成活大量繁衍,短期内恢复正常肤色。

三维白癜风CT是基于光学聚焦原理,利用计算机三维断层成像技术,直观实时、动态的观测皮肤病发生、发展及其皮损情况的先进检测仪器。VivaScope? 3000能够采集细胞尺度活组织的图像和录像。这种非侵入性的"光学切片"能为临床工作者提供组织学检查之外的检查手段。

专业:专家解读,保证,专业白癜风专家坐诊,详细解读病情和制定个性化治疗方案。

准确:设备先进,疗效保证,高精度、先进无创性诊疗设备和仪器,治疗水平更科学、更准确。

三甲:为了更高效的服务于广大白癜风患者,医院开辟专门分型就诊区域,采用"一站式"服务流程,有高素质护士提供优质导诊服务

快速:为了更高效的服务于广大白癜风患者,医院开辟专门分型就诊区域,采用"一站式"服务流程,使整个过程更规范、更人性,大大缩短您的就医等候时间。

舒适:人性化环境设计,温情舒适;个性化诊疗,系统化治疗回访与皮肤健康管理,全面周到。实行永久性健康档案数据管理、健康预警和提醒服务。

江苏白癜风治疗案例
张玉,30岁,江苏人,是公司一名白领,脖子上患白癜风六年多了,到处求医不见好转,一度对治疗白癜风失去了信心,一次上班途中偶从同事口中……

终于穿上漂亮凉鞋了!
张某,女,23岁,脚上长了白斑,家人无病史,刚开始还以为是普通的白点儿,过些日子应该就会好了,没想到,白斑越来越大,有两块钱币大小的白……

白癜风让女儿陷入人生低谷!
张教授和李老师分别为上海市两所高校任教,有一个漂亮的女儿,大学毕业后,幸运地应聘到一家外资企业工作,经过几年的努力打拼,终于成了老板助理……

白癜风医院选择很重要!
在武警上海总队医院皮肤科专家朱礼桃主任就诊治疗中心,张女士娓娓道来:"我的腰部白癜风发现有四年多了,起初只是一些小白点,没在意,过了四五……

![]()
![]()


 单一技术,不注重长远疗效。往往疗效慢、疗程长、治好几率低。通过干细胞自主更新、分化能力,注重对症施治的重要性。同时双向调节机体免疫,增加抵抗能力
单一技术,不注重长远疗效。往往疗效慢、疗程长、治好几率低。通过干细胞自主更新、分化能力,注重对症施治的重要性。同时双向调节机体免疫,增加抵抗能力 一般在一年以上。一般在3个月治疗左右白斑消失。
一般在一年以上。一般在3个月治疗左右白斑消失。 这种模式往往疗效慢、疗程长、治好几率低,易产生了抗药性、耐药性几乎不产生免疫排斥,成功率高。迅速根除修复白斑,对人体无任何副作用,且治好后不复发,手术危险性小,可操作性强,创伤小
这种模式往往疗效慢、疗程长、治好几率低,易产生了抗药性、耐药性几乎不产生免疫排斥,成功率高。迅速根除修复白斑,对人体无任何副作用,且治好后不复发,手术危险性小,可操作性强,创伤小 都有很大程度的,破坏了正常皮肤细胞的生长分裂,轻者出现骨质疏松、脱发、恶心等症状对人体无任何副作用,且治好后不复发等优势
都有很大程度的,破坏了正常皮肤细胞的生长分裂,轻者出现骨质疏松、脱发、恶心等症状对人体无任何副作用,且治好后不复发等优势 单次治疗费用不高,但治疗次数多,总价高。由于治疗疗程少,减少复发率所以总价低于单一治疗的方法。(医院为国家定点医保单位)
单次治疗费用不高,但治疗次数多,总价高。由于治疗疗程少,减少复发率所以总价低于单一治疗的方法。(医院为国家定点医保单位) 以效果不理想,容易复发。在不破坏皮肤组织的前提下,针对性治疗,从根本上杜绝了复发的可能性。
以效果不理想,容易复发。在不破坏皮肤组织的前提下,针对性治疗,从根本上杜绝了复发的可能性。


















 石家庄远大中医皮肤病医院是河北省引进美国Xtrac-308准分子激光治疗系统的白癜风治疗专科医院,美国Xtrac-308准分子激光治疗系统有效的解决了白癜风医疗形势,据记者调查了解308准分子激光治疗系统集成了308nmXeCI准分子激光光源、200Hz的准连续纳米调制、新的液体光源传输(LLG)等多项世界顶级技术。这套治疗系统采用的是XeCI准分子气体,堪称是目前世界皮肤激光治疗系统的颠峰之作。
石家庄远大中医皮肤病医院是河北省引进美国Xtrac-308准分子激光治疗系统的白癜风治疗专科医院,美国Xtrac-308准分子激光治疗系统有效的解决了白癜风医疗形势,据记者调查了解308准分子激光治疗系统集成了308nmXeCI准分子激光光源、200Hz的准连续纳米调制、新的液体光源传输(LLG)等多项世界顶级技术。这套治疗系统采用的是XeCI准分子气体,堪称是目前世界皮肤激光治疗系统的颠峰之作。

黑色素细胞种植成活疗法,运用世界先进的技术,高度浓缩提纯而成,药效直接作用于血液中,从患者自体细胞中分离出活性黑色细胞,运用国际前沿的治疗系统将足量的黑色素细胞准确种植与白斑病灶,同时提供多种黑色素营养液,保证黑色素细胞成活,分裂,恢复自我养护功能。
黑色素细胞种植成活疗法,运用世界先进的技术,高度浓缩提纯而成,药效直接作用于血液中,从患者自体细胞中分离出活性黑色细胞,运用国际前沿的治疗系统将足量的黑色素细胞准确种植与白斑病灶,同时提供多种黑色素营养液,保证黑色素细胞成活,分裂,恢复自我养护功能。

 供皮区选择腹部、臀部、股部等非暴露部位皮肤,采用负压吸引、液氮、局部PUVA照射或者药物刺激等方法使局部皮肤起疱,从而达到真表皮分离的目的。受皮区白斑目前多采用皮肤磨削术将表皮去掉……
供皮区选择腹部、臀部、股部等非暴露部位皮肤,采用负压吸引、液氮、局部PUVA照射或者药物刺激等方法使局部皮肤起疱,从而达到真表皮分离的目的。受皮区白斑目前多采用皮肤磨削术将表皮去掉…… 用取皮刀在供皮区获取约1微米厚度的极薄皮片,从而达到仅取表皮的目的,临床上以稍见点状出血为度。受皮区仍采用磨削法处理,然后用所取皮片覆盖。这种方法的优点是操作简单、手术时间大……
用取皮刀在供皮区获取约1微米厚度的极薄皮片,从而达到仅取表皮的目的,临床上以稍见点状出血为度。受皮区仍采用磨削法处理,然后用所取皮片覆盖。这种方法的优点是操作简单、手术时间大……
















